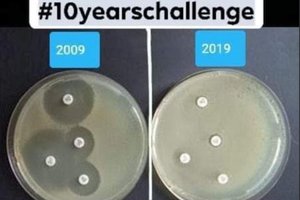
Medikų nuotraukose – įspėjimas apie visiems gresiantį didelį pavojų

Grįžtame į laiką, kai antibiotikų tiesiog nebuvo
K. Garuolienės aiškinimu, atsparumas antibiotikams yra natūralus procesas, tačiau netinkamai vartojant šiuos vaistus atsparumas didėja, o gydyti ligas tampa sunkiau. Būtent dėl šios priežasties, tvirtina K. Garuolienė, siūloma medikus, kurie per metus pacientams paskiria mažiau antibiotikų, nei nustatyta riba, skatinti finansiškai.
Pašnekovė pateikia pavyzdį – Lietuvoje vis sunkiau gydyti tuberkuliozę, nes, atsiradus atsparumui antibiotikams, geriami vaistai neturi jokio poveikio: „Mes grįžtame į tą etapą, kai antibiotikų nebuvo. Žmonės tiesiog dažnai gali ir mirti. Kita problema, kad atsparumas antibiotikams didina sveikatos priežiūros kaštus ir dėl to miršta žmonės.“
Skaičiuojama, kad Europos Sąjungoje dėl atsparumo antibiotikams kasmet nustatoma iki 25 tūkst. mirties atvejų. Be to, antibiotikams atsparūs žmonės negali būti gydomi įprastu būdu, todėl naujų technologijų naudojimas ar kitos reikmės kasmet papildomai kainuoja iki 1,5 mlrd. eurų.
Valstybinės ligonių kasos Paslaugų ekspertizės ir kontrolės skyriaus atstovė Oksana Burokienė pritaria – įvedant gero darbo rezultato rodiklį skiriamų antibiotikų kiekis turėtų mažėti. Šiuo atveju tai būtų taikoma, kai pacientas – vaikas iki septynerių metų. Be to, siekiama, kad pirmiausia būtų skiriami siauro veikimo spektro antibiotikai.
„Mūsų duomenimis, 60 proc. vaikų iki septynerių metų, kurie sirgo viršutinių kvėpavimo takų infekcijomis, buvo gydyti antimikrobiniai vaistais. Iš jų tik 9 proc. sudarė siauro veikimo spektro antibiotikai. Švedijos pavyzdys – kai skiriamas gydymas antimikrobiniais vaistais, ten pradedama būtent nuo siauro veikimo antimikrobinių vaistų. Šis rodiklis yra apie 80 proc.“, – sako O. Burokienė.
Vis dėlto LRT RADIJO klausytojams kyla abejonių, ar įvedus tokią skatinimo sistemą nenutiks taip, jog medikai antibiotikų neskirs net tada, kai tai yra būtina, nes paprasčiausiai norės gauti finansinę paskatą. Taip pat keliamas klausimas dėl medikų kompetencijos – jeigu dėl antibiotikų vartojimo atsparumas jiems didėja, kodėl medikai vis tiek skiria šiuos vaistus, kai tai ir nėra būtina?
Susiję straipsniai
Siūlomą finansinę paskatą vertina skeptiškai
Vilniaus universiteto (VU) Biochemijos ir molekulinės biologijos katedros vedėja profesorė Edita Sužiedėlienė vertindama planus finansiškai skatinti medikus, kurie neviršys antibiotikų skyrimo normų, sutinka – idėja valdyti atsparumą yra puiki, tačiau mintį skirti finansinį paskatinimą ji vertina skeptiškai.

123rf nuotr
„Nesu visiškai tikra, kad tokio finansinio skatinimo būdas yra pats geriausias. Mano, kaip mokslininkės, žvilgsnis krypsta į pačių gydytojų motyvacijos ir dalykinės kompetencijos didinimą, o ne finansinio skatinimo. Šituo klausimu dar tikrai vertėtų diskutuoti su įvairių sričių atstovais: tiek mokslo, tiek politikos, tiek medicinos ir t. t. Tikrai nevienareikšmis atsakymas“, – tvirtina E. Sužiedėlienė.
Jos įsitikinimu, ligoninės medikų, kurie dažnai susiduria su atsparumo antibiotikams problema, kompetencija tikrai yra pakankama, kad jie galėtų įvertinti, kokiais atvejais, kokiomis dozėmis ir kokius antibiotikus skirti. Mokslininkė atkreipia dėmesį – ligoninėse taip pat veikia ir diagnostikos padaliniai, infekcijų kontrolės tarnybos, todėl tretinio lygio įstaigose perteklinio antibiotikų skyrimo problemos neturėtų būti.
„Tikrai tų tarnybų kompetencija yra aukšta, nes jos laikosi visų reikalavimų, kurie iš esmės taikomi ir kitų pasaulio šalių (tarp jų – ir esančių Europoje) klinikinėse įstaigose. Kas liečia šeimos gydytojus, žinoma, jų darbo krūvis ir jų užimtumas tikrai turbūt neleidžia tiek gilintis į atsparumo antibiotikams problemą“, – svarsto E. Sužiedėlienė.
Vis dėlto ji įsitikinusi – būtent šeimos gydytojų dalykinę kompetenciją šiuo klausimu kelti būtina: „Galima būtų tikrai atkreipti dėmesį į šią sritį ir tą dalykinę kompetenciją gilinti daug geriau ir intensyviau, atsižvelgiant į paskutines tendencijas, kas vyksta su tuo atsparumu pasaulyje, kokios valdymo priemonės gali būti taikomos, pavyzdžiui, dirbant su visuomenėje paplitusiais sukėlėjais, kurių nešiotojai yra žmonės.“
Mokslininkė akcentuoja – jau dabar tvirtėja nuomonė, kad bakterijų atsparumas antibiotikams didėja ne tik dėl to, kad žmonės pradėjo vartoti daugiau antibiotikų. Bakterijos paprasčiausiai greitai prisitaiko, todėl net ir vartojant mažiau antibiotikų, jos galiausiai prie jų prisitaikytų ir taptų atsparios.
„Mikroorganizmai savo genomuose jau yra susirinkę galingus prisitaikymo mechanizmus. Bet, jeigu aš jų neskatinsiu, tai jie ir nepasireikš arba ne taip greitai pasireikš. Vadinasi, nuo mūsų irgi nemažai priklauso, kad neišleistume to džino, kuris glūdi mažų mikroorganizmų genomuose, iš butelio. Mes taip pat galime tikrai sąmoningai tai kontroliuoti“, – tvirtina E. Sužiedėlienė.
Tikina – antibiotikus dažniau skiria vyresnės kartos medikai
Šeimos gydytoja iš Aukštadvario pirminės sveikatos priežiūros centro J. Dūdienė atkreipia dėmesį, kad per dažno antibiotikų skyrimo problema skiriasi ne tik skirtingo lygio gydymo įstaigose, bet ir priklauso nuo medikų kartos.
„Kaip žmonės pasidžiaugia, visko neišyrę jaunesnės kartos medikai antibiotikų be reikalo nerašo arba net stengiasi to iš viso išvengti ir gydyti kitaip. [...] Vyresnės kartos gydytojai gal iš to atsargumo, gal iš įpročio, ką yra atsinešę iš ankstesnių medicinos metų, kai būdavo iš tikrųjų ir to atsparumo daug mažiau, tai gal buvo ir tebėra tokių gydytojų, kurie dažnai skiria“, – sako J. Dūdienė.
Ji taip pat pabrėžia, kad paminėta statistika, jog 60 proc. vaikų iki septynerių metų, kurie sirgo viršutinių kvėpavimo takų infekcijomis, buvo gydyti antimikrobiniai vaistais, nėra tiksli. Anot medikės, Valstybinės ligonių kasos statistika nurodo 57 proc. rodiklį, tačiau net ir jis neatitinka realybės.
Kaip aiškina medikė, į statistiką patenka išrašyti kompensuojamieji vaistai, tačiau statistika neapima visų vizitų: „Tikrai patenka ne visi: pakartotiniai vizitai nepatenka. [...] Statistika tikrai yra netiksli, nes tada išeina, kad kas antram vaikui išrašome antibiotikus. Taip tikrai nėra.“
Valstybinės ligonių kasos atstovė O. Burokienė patikslina – statistiką nurodė suapvalinusi, o rodiklis apskaičiuojamas išvedus bendrą skirtingų įstaigų rodiklį.
J. Dūdienė atkreipia dėmesį, kad neretai antibiotikų prašo ir patys pacientai. Ji pasakoja susidūrusi su situacija, kai, išgirdę apie siūlymą skatinti medikus neskirti antibiotikų, kai tai nėra būtina, pacientai tiesiog pareiškė antibiotikus įsigysiantys kaimyninėje šalyje.
„Pacientų, kurie ateina ir prašo išrašyti antibiotikų, pasitaiko kiekvieną dieną. Man teko tiesiog vakar kalbėtis su būreliu senjorų, kur viena moteris, perskaičiusi straipsnį, kad gydytojai bus skatinami išrašyti kuo mažiau antibiotikų, sako: „daktare, jūs nepergyvenkite, buvome Baltarusijoje ir iš ten parsivežėme antibiotikų, kurie ir nuo gerklės skausmo labai padeda, ir viską“, – pasakoja J. Dūdienė.
Anot jos, taip pat neretai pasitaiko atvejų, kai pacientai nesuvartoja viso jiems paskirto kurso, o ligai atsinaujinus ar susirgus vėl savarankiškai pradeda vartoti užsilikusius vaistus. Medikės aiškinimu, paprastai, pradėjus vartoti antibiotikus, geriau žmonės pasijaučia jau antrą ar trečią dieną, todėl kursą nutraukia. Tai galiausiai lemia, kad ne tik ligos yra sunkiau gydomos, bet didesnis pavojus kyla ir aplinkiniams.
„Pacientas jaučiasi pasveikęs, tačiau bakterijos nėra išnaikintos. Čia tos, kurios likusios, kaip tik ir užsiaugina atsparumą tam antibiotikui, kurį pacientas vartojo. Kas toliau vyksta? Tas pacientas savo rate, aplinkoje skleidžia tas bakterijas [...] ir tada jau reikia vartoti stipresnius antibiotikus. Tas užburtas ratas – labai skausminga tema visai visuomenei“, – nurodo J. Dūdienė.
Parengė Vaida Kalinkaitė-Matuliauskienė